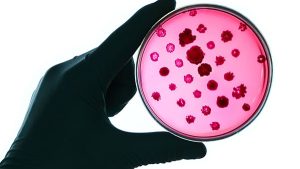

HIGH EFFICIENCY COATING MATERIAL IN ANTIBACTERIAL SURGICAL SUTURES: CHLORHEXIDINE
Sutures can cause severe surgical site infections…
Sutures can cause severe surgical site infections…

In a recent study published in the journal Science Translational Medicine, biocompatible and…

Kese ağzı dikişi yuvarlak yara dokularında kapama amacıyla torba büzme ipi gibi kullanılan devamlı…

Bu sütür tekniği genellikle bir dikişin gerginliğini daha büyük bir yüzey alanına dağıtmak için…

1800’lü yılların başında Fransa’da operasyonlarını yürüten Antoine Lembert, intestin dikişi…

Çapraz bağlı sütür tekniğinde 14 adım vardır: 1 -İğneyi insizyonun uzak tarafındaki deriden geçirilir…

Cerrahi operasyonlarda uygulanacak sütür tekniği, yara tipine ve bölgesine göre farklılık göstermektedir…

Ford interlocking dikiş tekniği, basit sürekli dikişe çok benzer, ancak bir sonraki dikişi atmadan önce…

William Halsted, M.D. (1852-1922), adını taşıyan temel cerrahi prensiplerini geliştiren, yenilikçi bir…

Horizontal matris sütürun devamlı versiyonu, yaradaki gerilimi tüm sütür hattında dağıtır. Bu sütür…

